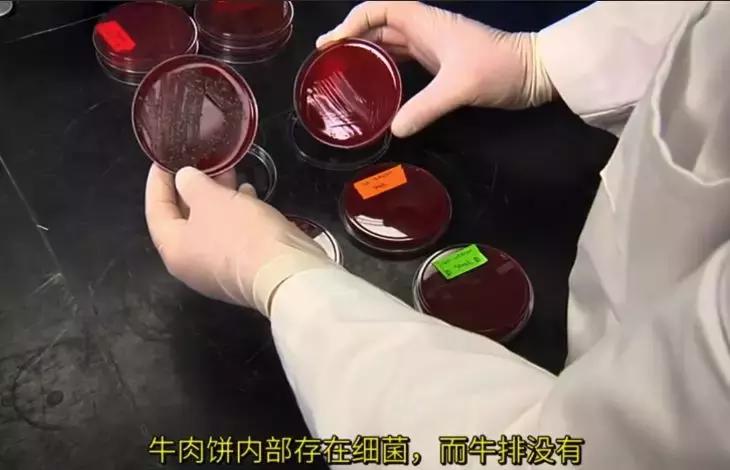
几块钱的牛排,几块钱的原切牛排

大家好,我是虫妈潘宇。
下面是固定广告时间:
在儿童发展心理学里,写行业观察我是最深刻的;
深度洞察行业的人里,写儿童心理我是最专业的;
谢谢大家,以下是今天的文章。
【虫妈原创深度观察文章,谢绝转载】
01
相信大家在微信群里,
会经常看到有人分享一些拼团链接,
比如广大人民群众喜闻乐见的拼夕夕。
前段时间我在小区的业主群里,
就看到这么一个拼团链接:

好奇害死猫,
点开链接看到最新价格后,
我不但下巴,
连眼珠子都掉下来了:

39.9元,6份牛排!!
换算下来还不到7块钱一块!
还送煎锅、刀叉、黄油、番茄酱!
还包邮!
果然是上拼夕夕,
刷新对低价的认知。
在评价区可以看到,
很多人买这种牛排,
是给孩子吃的:



拼夕夕的流量相当高,
再加上价格这么便宜,
不用想都知道这些牛排的销量会很惊人,
比如上面那款牛排销量高达4万:

虽然我们是穷产阶级,
目前还吃不上雪花满满的M9、A5牛排,
但是六七块钱一块的牛排,
也太实惠了吧,
这里头有什么猫腻吗?
02
原来,根据我们国家的标准,
牛排按照加工方式不同,
分为原切牛排和重组牛排。
不难理解,
原切牛排,
就是牛肉不经过任何预加工,
直接切割包装成一块块牛排,
简单来说就是生鲜肉。

原切牛排
而重组牛排,又叫合成牛排,拼接牛排,
也很容易理解,
就是把牛肉的边角料,
用食品添加剂,
例如卡拉胶、谷氨酰转氨酶、碳酸氢钠、木薯粉等等,
再加上水和调味料这些,
与牛肉碎搓成一团,
它们的蛋白质分子就会发生交联,
肉肉就粘合在一起了:

把这坨粘合好的肉柱子冰冻后,
切成一块一块,
就成了重组牛排了:


现在已经发展到机械化生产,
把肉碎和添加剂放进去,
一个小时后就能生产出整块的肉。

大家发现没有,
重组牛排基本都是圆的。
显而易见的原因啊,
一个柱体最方便加工了嘛,
切成块就是圆形的了。
所以我们看回文章开头的那个牛肉,
虽然产品介绍页面是这样的:

但是我们去评价区看看买家晒单:

果然啊也是圆的,
毫无疑问是重组牛排了!
这种用肉碎拼接起来的重组牛排,
价格便宜很多。
有多便宜呢?
大家知道,
南美洲很多国家,
地广人少青草密,
养牛羊基本就是放养,
没啥成本,
所以价格很有优势。
我给大家看看阿里巴巴上面,
进口乌拉圭冻牛肉的价格:

每公斤30块钱,一斤15块钱!
其实,
如果是*私走**进来的牛肉,
或者是质量更差的老牛肉、碎牛肉,
价格会更低。
所以,
一块130克的重组牛排,
成本可以稳稳地控制在3块钱以内。
加上刀叉、调味料、快递费,
一块牛排卖六七块钱,
商家还是有钱赚的。

03
那么,
这种便宜到爆的重组牛排,
里面还有那么多添加剂,
究竟能不能买来吃呢?
比如有人说,
这些添加剂,
影响人体对钙的吸收,
会导致骨质疏松。
在这里,
虽然是一位孩子妈妈,
但是作为一名理科生,
我的态度是明确的:
重组牛排在国外也存在,
如果是严格按照国家标准生产出来的重组牛排,
大家但吃无妨。
因为添加剂不是毒药,
在标准量之内添加,
食品没有任何安全问题!
比如,
用在重组牛排的复合磷酸钠(三聚磷酸钠、六偏磷酸钠),
并不会阻碍身体对钙的吸收,
甚至在国家标准里,
都没有规定添加的上限。
并且,像盐一样,
这种东西多了就会影响口感,
厂家也不傻,随便添加。
但是,
在中国最怕的就是但是了。
但是就怕那些小厂家乱来。
怎么乱来呢?
例如,
在成分表之外,
添加禁用的食品添加剂。
大家对成分表可能不太了解,
以为产品都会严格按照成分表生产。
但实际上,
成分表是在申请食品生产许可时,
提交给食品监管部门留底的,
那时候监管部门可能会检查一下。
但是到了正式生产后,
监管力度就没多强了,
毕竟人手有限,
或者地方保护、不作为等等原因,
生产过程基本就靠生产者的自觉了。
这些是我一个家里开食品加工厂的闺蜜告诉我的。

这些生产地址在某个村子里的牛排,你放心吗
又例如,在牛肉里添加成本更低的其它肉类。
前年,
在上海就发生过这么一件事,
一间连锁牛排店,号称年销售上百万块牛排,
被人举报用重组牛排。
这家店来了个骚操作,
他们认为重组牛排并不犯法,
于是主动把自己的产品送到工商局检验。
结果,
在牛排中检测出鸭肉成分!
最后这家店被停业整顿。


写到这,
我想起了有一次逛商场,
虫虫看到某家店装修比较炫目,
非要拉着我进去吃饭。

虽然已经打码,相信有小伙伴知道是哪个牌子(图片网上找的)
进去一看,那里的套餐是真便宜啊!
一个59元的套餐,
包含一份牛排,
还有别的小吃、甜品啥的,
当时就隐隐觉得价格太过于便宜了。
现在回头看,
基本不用怀疑,
当时吃的肯定是重组牛排了。
至于里面有没有别的肉,
那就自祈多福吧。
04-最后的建议
就像我在前面说的,
并不是说重组牛排一定不能吃。
大家在购买的时候,
尽量挑选大一点的牌子。
可惜没人找我打广告,
我也不知道推荐什么品牌比较好。
另外,无论是原切牛排还是重组牛排,
能买新鲜的,就不买腌制的。
因为腌制过的牛排,
肉质新鲜与否都看不出来了,
尤其是超市里卖的散装腌制牛排,
大概率是用卖剩的牛肉拼合成的。
最最最重要的是!!!!
重组牛排不能生吃!
要完全煮熟才能食用!
这是因为,
原切牛排,
内部是基本不会有细菌的,
所以只要稍稍煎一下表面,
就能放心食用。
但是,
重组牛排是牛肉碎拼成的,
内部会有细菌!
俄亥俄州立大学的实验
2009年在日本,
一间牛排连锁餐厅就因为没有煮透重组牛排,
而发生大肠杆菌中毒事件。
世界各地的食品部门都建议,
这种牛排一定要熟透后才能食用。
在日本,
甚至已经把这个要求写进了法律,
把它作为餐厅的义务。
我们回到本文开头的那个牛排链接,
在详情页,
我们却看到这么一个图片:

商家建议煎至5到7成熟食用
作为销售了几万份的商家,
大家觉得,
他们真的不知道重组牛排怎么吃最安全吗?
我不相信。
他们只是不愿意说透罢了。
所以,又回到前面那个灵魂拷问:
仅仅靠生产者自觉遵守规定,真的能让我们放心吗?